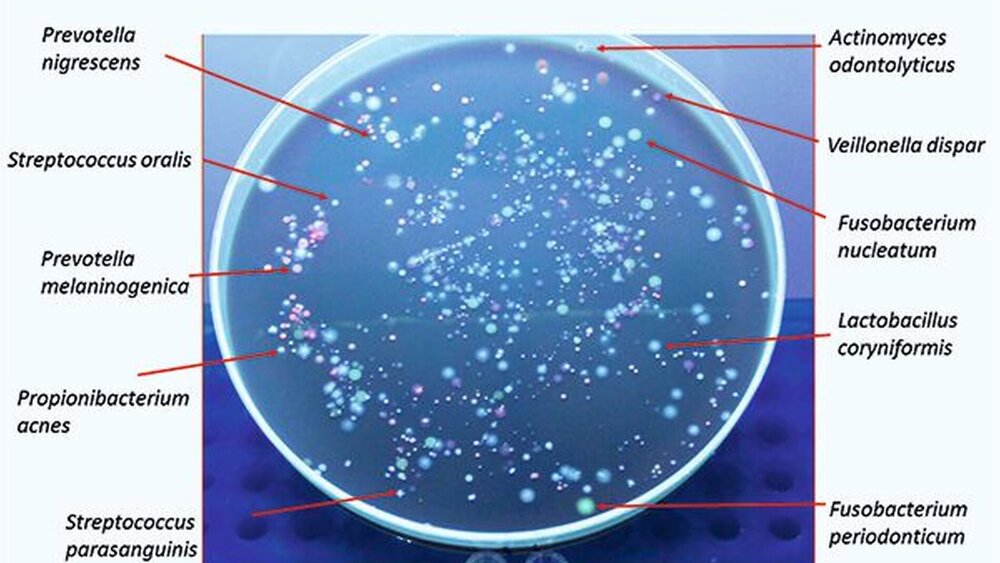

Das orale Mikrobiom und seine kariogenen Spezies
Am Lehr- und Forschungsgebiet Orale Mikrobiologie und Immunologie in Aachen untersuchen wir die Veränderungen im oralen Mikrobiom unter verschiedensten Bedingungen (zum Beispiel gesund versus Parodontitis beziehungsweise Karies; auf verschiedenen Substraten wie Dentin, Schmelz, Kompositen; nach Zugabe von Antibiotika oder Probiotika) und mit Kultur-basierten wie auch molekularen Methoden. Meist erschließt sich das Resultat nicht auf den ersten Blick, sondern es sind aufwendige statistische Berechnungen nötig, bevor ein Zusammenhang deutlich wird. Untersucht man hingegen den Einfluss von Zucker (Saccharose) auf die Entwicklung des Speichelmikrobioms, so fällt das Ergebnis so eindeutig aus, dass auch ein Laie das Resultat sofort begreift. Diesen Versuch möchte ich als Einleitung zum Thema kurz präsentieren.
Das Saccharose-Experiment
Für ein vom Bundesforschungsministerium gefördertes Verbundprojekt hatten wir in Aachen die Aufgabe, das Speichelmikrobiom außerhalb der Mundhöhle in vitro für mindestens 18 Stunden möglichst unverändert zu bewahren, um neue antimikrobielle Substanzen in ihrer Wirkung auf das Mikrobiom ex vivo zu testen [Conrads et al., 2019a]. Wir haben dazu unter anderem Mikrobiom-Proben auf verschiedenen Nährmedien mit und ohne Zuckerzusatz (0,5 Prozent Saccharose) getestet. Hintergrund: Prinzipiell gibt es 700 bis 800 verschiedene orale Bakterienarten, wovon jedoch nur die Hälfte kultivierbar ist [Dewhirst et al., 2010]. Die Gründe dafür liegen in den unbekannten Nährstoffansprüchen vieler Keime und auch in fehlenden Möglichkeiten, die Keime nach Überführung auf eine Agarplatte von obligatorischen, symbiontischen Begleitorganismen zu trennen.
Alle Menschen haben ein gemeinsames Kern-Mikrobiom aus besonders erfolgreichen „essenziellen“ Spezies. Daneben existiert in jedem oralen Mikrobiom eine individuell-spezifische Auswahl zusätzlicher Keime im Sinne eines personalisierten mikrobiellen Fingerabdrucks. Neben den individuellen gibt es auch standortspezifische und zeitliche Unterschiede in der Zusammensetzung des Mikrobioms. Letztere sind zum Beispiel vom Rhythmus der Nahrungsaufnahme abhängig. Von mir persönlich weiß ich, dass ich 280 Bakterienarten im Biofilm und 215 Bakterienarten im Speichel besitze, davon etwas weniger als die Hälfte (geschätzt 100) prinzipiell kultivierbar. Mit nährstoffreichen Standard-Agarplatten lassen sich davon ungefähr 60 Arten anzüchten.
Abbildung 1 gibt einen exemplarischen Überblick über ein normales Speichelmikrobiom. Es ist hier dargestellt nach Bestrahlung mit UV-Licht. Dadurch fluoreszieren einige Bakterienarten charakteristisch, zum Beispiel Fusobakterien gelb-grünlich, pigmentierte Prevotellen rot-orange oder Veillonellen violett.
Abbildung 2 zeigt das Mikrobiom nochmals auf einem Blutagar ohne Fluoreszenz, dafür aber im Vergleich ohne (links) und mit Zugabe von 0,5 Prozent Saccharose (rechts). Aus ungefähr 60 verschiedenen Bakterienarten, die vorher in der Kultur sichtbar waren, blieben bei dem skizzierten Versuch nach Zugabe des Zuckers nur zwei bis drei Arten übrig. Die nähere Analyse ergab, dass es sich um Laktobazillen, Bifidobakterien und einige wenige, besonders säuretolerante Streptokokken handelte.
Das gesunde Mikrobiom ist nach der Zugabe von Zucker also binnen weniger Stunden kollabiert und geschrumpft auf wenige saccharolytische, azidogene, azidophile Arten. Die gute Nachricht: Während in der Labor-Kultur nach Absterben der Begleitkeime eine Rekonstitution des gesunden Mikrobioms nicht mehr möglich ist und tatsächlich nur wenige azidurische Keime übrig bleiben, kann sich in der menschlichen Mundhöhle ein gesundes Mikrobiom schnell wieder regenerieren, beispielsweise wenn man die schädlichen niedermolekularen Kohlenhydrate eine Zeit lang weglässt und sich ausgewogen ernährt.
Der Standort Mundhöhle
Die menschliche Mundhöhle ist reich an Mikroorganismen. Im Unterschied zu anderen Standorten wie Haut, Darm oder Genitale bietet der Mund verschiedenste Umweltbedingungen nebeneinander. Allein die Temperatur ist mit 36,3 bis 38°C festgelegt. Es gibt hingegen Gradienten von Sauerstoff, die von einem Anteil von 21 Prozent bis hinunter zu 0 Prozent reichen (entspricht Anaerobiose mit sehr niedrigem Redoxpotenzial im Bereich von -300 mV). Es gibt dazu kreuzend pH-Gradienten (von pH 4,5 bis über pH 8 [Schläfer et al., 2011]) und alle möglichen Abstufungen von Zucker-, Protein- und unzähligen Supplement-Konzentrationen. Dies erklärt die mikrobielle Vielfalt im oralen Mikrobiom.
Der Mund ist als Standort begehrt, obwohl er durch die Komponenten der Immunabwehr den Keimen das Leben nicht immer einfach macht. Neben den bereits vorgestellten Bakterien finden wir regelmäßig Archaeen (methanogene Archebakterien), humanpathogene Viren, Bakterienviren (Phagen), Schimmel- und Hefepilze und sogar einzellige Protozoen in der Mundhöhle [Bandara et al., 2019; Horz und Conrads, 2011; Lauritano et al., 2016; Motlagh et al., 2016]. Abbildung 3 gibt einen Überblick über den Stammbaum des Lebens, der aus drei Domänen besteht (Eukaryota, Bacteria und Archaea), und zeigt, welche dieser Keime bei der Karies und welche bei der Parodontitis eine Rolle spielen.
Univ.-prof. Dr. rer. nat. Georg Conrads

1994: Promotion zum Dr. rer. nat. über Gensonden in der medizinischen Diagnostik (RWTH Aachen)
1995: Forschungsaufenthalt in London (EDI)
1999: Habilitation für das Fach Medizinische und Orale Mikrobiologie (RWTH)
2000–2002: Visiting Professor an der University of California in Los Angeles (UCLA)
seit 12/2002: Universitätsprofessor (RWTH) für das Fach Orale Mikrobiologie und Immunologie
Conrads ist Gutachter für zahlreiche Institutionen sowie board member beim Journal of Oral Microbiology und Anaerobe Journal. Er ist seit 2016 Träger des Walkhoff-Preises der Deutschen Gesellschaft für Zahnerhaltung.
Die gegensätzlichen Eigenschaften des mikrobiellen Einflusses auf die Entstehung von Karies (Zuckerabbau, supragingivale Lage, leicht aerob bis anaerob) und Parodontitis (Proteinabbau, subgingivale Lage, anaerob) spiegeln sich interessanterweise in der phylogenetischen Herkunft der Erreger wider: Karies ist eher mit gram-positiven Bakterien und eukaryotischen Hefen der oberen Stammbaumhälfte assoziiert, während Parodontitis eher mit gram-negativen Bakterien und methanogenen Archaeen der unteren Stammbaumhälfte assoziiert ist.
Wie Bakterien Energie gewinnen
Mikrobielle Gärung und Säureproduktion
Um Ordnung zu erhalten und erst recht um sie zu erzeugen, benötigt man bekanntermaßen Energie. Um Leben zu ermöglichen, benötigt man Stoffwechselenergie in Form von Adenosintriphosphat (ATP), die Energiewährung der Zellen. Leben erzeugt (regeneriert) sein ATP entweder über Atmung (sehr effizient), Photosynthese (effizient, wenn genügend Licht vorhanden ist) oder über die Gärung (ineffizient). Bei der Kariogenese spielen gram-positive Bakterien und saccharolytische Hefepilze eine besondere Rolle (Abbildung 3).
Die meisten Bakterien und Hefen gewinnen ihre Energie durch die mühselige Fermentation (Vergärung) von Zuckern und zuckerreichen Glykoproteinen. Karies ist also unmittelbar ein Ergebnis der pH-senkenden Wirkung von Gärungsendprodukten.
Um die mikrobielle Kariesätiologie zu verstehen, muss man sich mit der Gärung und dort speziell mit der Milchsäuregärung befassen [Lagerweij und van Loveren, 2020; Marshall, 2019]. Viel Energie wird freigesetzt, wenn man – wie in einer Wasserstoffzelle – H2 und O2 (beziehungsweise einen anderen H2-Akzeptor wie Nitrat, Pyruvat, Acetyl-Coenzym A, Acetaldehyd) zusammenbringt. Bei der Gärung werden während der Glykolyse die Zucker so gespalten, dass molekularer H2 entsteht und gleichzeitig ein H2-Akzeptor. Dann wird abschließend H2 auf Akzeptoren wie Pyruvat (zu Milchsäure), Acetyl-CoA (zu Essigsäure) oder Acetaldehyd (zu Ethanol) übertragen und die freiwerdende Energie als ATP gespeichert. Das geht schnell, ist aber ineffizient, da der Abbau früh gestoppt wird und nur ein bis vier Moleküle ATP pro Molekül Glucose (also zwei bis acht Moleküle ATP pro Molekül Haushaltszucker, Saccharose) gebildet werden. Eine menschliche Zelle holt da locker neunmal mehr Energie heraus, indem sie über Zitratzyklus und Atmungskette die organische Materie soweit abbaut, bis nur noch CO2 und H2O als Endprodukte verbleiben.
Die Ineffizienz zwingt gärende Keime dazu, viel Substrat umzusetzen und so entstehen bereits bei normalem Zuckerkonsum 30 bis 50 mg Milch-, Essig- und andere organische Säuren sowie Ethanol und CO2 pro Tag. Der menschliche Speichel könnte die Säure prinzipiell sehr einfach puffern, aber Diffusionsbarrieren – wie der Biofilm mit teils wasserunlöslichen extrazellulären Polysacchariden (Dextrane, Mutan) – behindern die Puffersysteme und so kommt es lokal zur Demineralisation, zur Schmelz-Primärläsion und schließlich zur Kavitation.
Was das Mikrobiom Kariogen macht
Quantitativ finden wir 100 Millionen Bakterien pro Milliliter Speichel beziehungsweise Milligramm Plaque. Der quantitative Eintrag erhöht sich mit der Nahrungsaufnahme und wird gesenkt durch Mundhygienemaßnahmen. Das ist jedoch hier nicht das Thema. Betrachten wir also die qualitative Zusammensetzung der bakteriellen Mundflora, das Mikrobiom, um darin nach bedeutsamen Unterschieden bei der Anfälligkeit für Karies zu suchen.
Die Mundflora besteht aus acht häufigen (Anteil > 1 Prozent aller Spezies und Taxa) und sehr vielen seltenen Bakteriengruppen, die wir Phyla nennen. Ein Phylum besteht aus mehreren Ordnungen, die aus mehreren Familien, die aus mehreren Gattungen, die aus mehreren Arten und schließlich aus mehreren Stämmen und unzähligen Isolaten bestehen. Für die Kariogenese kann man seine Betrachtung auf zwei bis drei Phyla (Firmicutes, Proteobakterien, Aktinobakterien) beschränken, was aber zusammen genommen 500 Arten sind, die etwa 65 Prozent der Mundflora ausmachen. Hinzu kommen noch die gärenden Hefepilze, wenn wir das prinzipielle kariogene Potenzial bewerten wollen. Damit sollte klar sein, dass wir eine säurefreie Mundhöhle niemals erreichen können. Eliminiert man einige der Top-Zuckerfermenter (Saccharolyten), so werden andere schnell diese Nische besetzen.
Man kann bei Mikroben-gerichteten, kariespräventiven Maßnahmen also immer nur das Schlimmste vermeiden, niemals aber alle Erreger eliminieren. Das ginge nur mit einer sterilen Mundhöhle, wie es bei gnotobiotischen Tierversuchen in der Tat praktiziert wurde, was aber außerhalb der Laborbedingungen unmöglich ist.
Was ist also das Gefährlichste was unser Mikrobiom in Sachen Kariesrisiko hergibt? Die reine Säureproduktion (Azidogenese) führt uns nach dem oben Erwähnten wohl eher nicht zum Ziel, denn sie ist einfach zu verbreitet. Spezifischer könnte man gesteigerte Laktatproduktionen an repräsentativen Zähnen pro Zeit messen, indem man die Aktivität des mikrobiellen Schlüsselenzyms Laktatdehydrogenase (LDH) bestimmt. Die LDH ist ein Enzym, das den Wasserstoff auf Pyruvat überträgt und damit die für die Kariogenese quantitativ und qualitativ besonders bedeutsame Milchsäure produziert (niedriger pKs-Wert von 3,86). Ansätze der LDH-Messung (In-vitro-Daten) hat unsere Arbeitsgruppe kürzlich publiziert [Walther et al., 2019] und In-vivo-Studien dazu wurden abgeschlossen [Walther et al., 2020, im Druck].
LDH-Messungen als Maß für das azidogene Potenzial sind aber kompliziert, denn es gibt viele LDH-Varianten (darunter D- und L-Formen, bakterielle und humane Formen), die zu unterscheiden sind, zudem werden die Enzyme an- und abgeschaltet, je nachdem, wieviel Zucker im Speichel ankommt beziehungsweise wieviel Laktat bereits vorliegt.
Karius und Baktus lassen grüßen
Die Rolle der Säuretoleranz
Da mag es zielführender sein, statt der Azidogenese die Säuretoleranz (Azidotoleranz, Azidophilie, Azidurie) zu betrachten. Die Eigenschaft der Azidotoleranz eines Mikrobioms wird eben nicht einfach an- und abgeschaltet, sondern ist nachhaltig und das Ergebnis kontinuierlichen schädlichen Zuckerkonsums (beziehungsweise ungenügender Mundhygiene).
Ein azidotolerantes Mikrobiom spiegelt also das Fehlverhalten eines Patienten in Sachen Ernährung und Hygiene wider und zeigt den Bedarf für Verhaltenslenkung durch das zahnmedizinische Personal. Wobei, nicht immer ist es nur Fehlverhalten, denn auch erbliche Komponenten wie Pellikel-Muster und Speichelflußrate sowie Speichelzusammensetzung können ein azidotolerantes Mikrobiom selektieren.
Hier sind wir dann bei altbekannten Karieserregern (Karius und Baktus aus den frühen Neunzigern lassen grüßen) wie Streptococcus mutans, Streptococcus sobrinus und Lactobacillus-Spezies (Laktobazillen). Hierzu gibt es unzählige Studien, die ihre hohe Azidotoleranz und andere Virulenzfaktoren wie Adhärenz und Produktion von extrazellulären Polysacchariden (siehe unten) hervorheben. Auch die Genome dieser Arten sind bestens untersucht [Conrads et al., 2014; Song et al., 2013]. Abbildung 4 verdeutlicht die zuckerbedingte stufenweise Entwicklung der Mundflora vom Normalzustand (Homöostase) über die azidogene hin zur azidurischen, azidophilen und weiter zur dysbiotischen destruktiven Phase.
Laktobazillen benötigen wir für den Säureschutzmantel der Schleimhaut-Epithelien im Mund – gleiches gilt für den Darm und die weibliche Genitale. Milchprodukte wie Joghurt und Käse wären ohne sie kaum denkbar, und auch Biersorten wie Berliner Weiße oder Leipziger Gose verleihen sie den typischen Geschmack. Auf die gleiche Weise vergären diese Milchsäurebakterien aber eben auch die Zuckerreste im Mund und schädigen damit die Zähne. Wenn man Laktobazillen (hohe Laktatproduktion und Säuretoleranz) zahnständig nachweist, so ist das ein akkurater (hohe Sensitivität und Spezifität) Hinweis auf Kariesprogression [Henne et al., 2015].
Bis heute, nach unzähligen Mikrobiomstudien zur Kariesätiologie, hat man noch weitere bedeutsame Arten ausgemacht, die azidogen, hoch-azidotolerant und für den Kariogenese-Prozess wichtig sind (Abbildung 3): Aktinomyzeten, Atopobium, Bifidobacterium und speziell auch Bifidobacterium dentium, Rothia dentocariosa, Parascardovia denticolens, Scardovia wiggsiae, Slackia exigua, sowie Streptococcus salivarius (und andere Streptokokken) [Henne et al., 2015]. Aktinomyzeten und Streptokokken sind Pioniere bei der Zahn- beziehungsweise Pellikel-Besiedlung und damit immer in der ersten Reihe, nahe am Zahn. Ihre Säureproduktion im Biofilm trägt immer zur Kariogenese bei.
Die Informationen zu den anderen gelisteten Taxa dürften interessanter und außergewöhnlicher sein. In einer Studie aus dem Jahr 2019 hat ein deutsches Forscherkonsortium ermittelt, dass Atopobium in Dentinläsionen um fast 15 Verdopplungsstufen erhöht war gegenüber gesunden Vergleichsproben und damit das Feld der kariogenen Spezies anführte [Wolff et al., 2019].
Die Arbeitsgruppe bestätigte auch die verlorene Diversität in zuckerprovozierten Bereichen der Mundhöhle von Kariespatienten, wie auch wir sie im einleitend beschriebenen Versuch gefunden haben. Bifidobakterien wiederum sind Probiotika für den Darm. In der Mundhöhle haben wir sie vermehrt in besonders tiefen Läsionen gefunden, und Bifidobacterium dentium scheint als Spätmarker der Dentinkaries geeignet [Henne et al., 2015].
Rothia dentocariosa hat sogar seinen Namen aufgrund der kariogenen Rolle erhalten. Es erzeugt seine Energie aus der Atmung, kann aber viele verschiedene Zuckerarten (außer Milchzucker) verstoffwechseln und kommt häufig in Läsionen vor [Jiang, 2016]. Scardovia wiggsiae (und der verwandte Parascardovia denticolens) ist ein „Rising Star“ am Himmel der Karieskeime und scheint bei frühkindlicher Karies eine Rolle zu spielen, während die Datenlage bei Erwachsenen heterogen ist. Er scheint den Synergismus mit S. mutans zu benötigen [Henne et al., 2015; Kressirer et al., 2017]. Slackia exigua schließlich ist der noch am wenigsten untersuchte „neue“ Karieserreger, da er schwer kultivierbar ist und so in Kultur-basierten Studien meist übersehen wurde. Nach den Ergebnissen molekularer Studien zeigt Slackia eine hochsignifikante (p = 0,002) Assoziation mit frühkindlicher Karies [Tanner et al., 2011].
Die Rolle extrazellulärer Polysaccharide
Neben der weit verbreiteten Säureproduktion und der schon etwas spezielleren Säuretoleranz ist als Drittes die Produktion wasserunlöslicher extrazellulärer Polysaccharide (EPS) bei der Kariogenese von Bedeutung. Zur Wiederholung: Ohne diese Diffusionsbarriere könnte die Säure den Zähnen nicht gefährlich werden, da wir genügend Puffersysteme (Karbonate, Phosphate, Histidin-haltige Proteine) im Speichel besitzen. Die Produzenten dieser EPS sind ebenfalls mikrobieller Natur.
Und hier kommen ein weiteres Mal die Mutans-Streptokokken (Sammelname für S. mutans, S. sobrinus und wenige andere nah-verwandte Streptokokken) ins Spiel. Diese haben ein ganzes Arsenal extrazellulärer Enzyme, die Glykosyltransferasen (GTF). Diese spalten Haushaltszucker, führen den Fruktoseanteil der Glykolyse und Gärung (siehe oben) zu und nutzen die bei der Spaltung freiwerdende Energie um den Glucoseanteil zu vernetzen. Dabei können je nach GTF-Variante wasserlösliche Dextrane (hauptsächlich C1-C6 glykosidische Bindungen), aber auch wasserunlösliche und damit besonders haftfähige Mutane (mit zusätzlichen C1-C3- und C1-C4-Seitenketten) entstehen [Conrads et al., 2014; Koo et al., 2009]. Mutane reduzieren die Diffusion der Speichelpuffer erheblich.
Nebenrollen: Helferkeime und Helfershelferkeime
Ein wenig kompliziert wird die Karies-Mikrobiomforschung, wenn man die Rolle von Helferkeimen und Helfershelferkeimen betrachtet. So kommen in kariösen Läsionen auch regelmäßig und in großer Zahl Bakterien vor, die eigentlich gar keine Zucker mögen, aber dennoch die Läsion als Standort bevorzugen. Die Veillonellen, Neisserien, Campylobacter und Propionibakterien zum Beispiel konsumieren die Säuren in Läsionen und suchen daher die Gesellschaft von Säureproduzenten. Wenn sie Säuren konsumieren, könnten sie eigentlich als anti-kariogen gelten, zumal sie – wie Veillonella parvula – aus der starken Milchsäure mildere Säuren erzeugen (Essig- und Propionsäure). Leider feuern sie aber durch ihren Säurekonsum die weitere Säureproduktion an, sie melken quasi die saccharolytischen Milchsäurebakterien, und die Endprodukt-Hemmung wird vermieden. Andere Spezies wiederum, wie Prevotellen, sind wenig saccharolytisch, aber erzeugen ein anaerobes Milieu, in dem Bakterien nur mit schnellem Substratumsatz zurechtkommen und dabei viel Säure produzieren.
Die antikariogenen Gegenspieler
In natürlich belassenen Systemen wird zumeist ein Gleichgewicht (Homöostase) erreicht. Das ist robust, wenn man es mit Noxen wie Zuckerkonsum bei der Karies oder Stress & Rauchen bei der Parodontitis nicht übertreibt. Wer stellt das Gleichgewicht bei vorübergehender Säureproduktion wieder her, wenn es nicht die oben beschriebenen Säurekonsumenten sind? Es sind ebenfalls Mitglieder des oralen Mikrobioms. Diese antikariogenen Gegenspieler erfüllen eine wichtige Rolle. Es sind ausgerechnet wieder Firmicutes und besonders einige Streptokokkenarten wie S. gordonii und S. dentisani, die bei einem Absenken des pH-Wertes unter 6,0 – also noch vor Erreichen des kritischen Wertes von pH 5,5 und bei zwingender Anwesenheit der Aminosäure Arginin – eine re-alkalisierende Kaskade, den arginolytischen Stoffwechselweg (Arginin-Diaminase-Weg), anwerfen.
Daneben sind diese Probiotika glücklicherweise zahnständig und produzieren zelleigene antimikrobielle Substanzen (Bacteriocine), die ihnen den Standort Zahn sichern und nebenbei unsere Zähne schützen [Camelo-Castillo et al., 2014; Conrads et al., 2019b]. Bacteriocine sind kleine antimikrobielle Peptide, die von Bakterien gebildet werden, um damit ihre direkten Nahrungskonkurrenten (und damit meist verwandte Arten oder Stämme) zu dezimieren, indem sie ihre Membran durchlöchern. Einige werden bereits industriell genutzt. Nisin zum Beispiel, von Lactococcus lactis produziert, wird als E234 Lebensmitteln wie Pudding oder Käse zugesetzt und schützt vor Listerien-Befall. Es gibt unzählige Bacteriocine. Eine Nutzung als Antibiotika ist prinzipiell möglich. Nachteilig ist ihre Hyperspezifität, so dass meist nur bestimmte Arten oder Stämme bekämpft werden, wie auch ihr allergisierendes Potenzial. S. dentisani produziert sogar elf Bacteriocine und mindestens zwei davon richten sich gegen S. mutans [Conrads et al., 2019b].
Fazit und Ausblick
Nur die moderne molekulare Mikrobiomforschung gibt uns ein Komplettbild aller bei der Kariogenese involvierten Spezies. Von der Mikrobiomforschung ist es ein konsequenter (Fort-)Schritt zur Metagenom- und Metabolomforschung. Dabei werden ebenfalls Spezies (Taxa) betrachtet, aber nun verbunden mit ihren Genom-kodierten Eigenschaften, darunter metabolische Funktionen wie Zuckerabbau und Säureproduktion, aber eben auch Adhärenzvermögen sowie EPS- und Glucan-Produktion. Auch gegenläufige Funktionen wie die Re-Alkalisierung durch das Arginin-Diaminase System sind damit erfassbar.
Ein therapeutisches Traumziel ist es, im gestörten Mikrobiom eines Patienten fehlende oder abhandengekommene metabolische Komponenten durch Zugabe von Probiotika wie S. dentisani wieder zu ersetzen. Ist das orale Mikrobiom auf diese Weise nicht zu reparieren, könnte man es durch eine natürliche oder künstliche Biofilm-Transplantation ersetzen – ähnlich der Stuhltransplantation zur Heilung einer pseudomembranösen Enterkolitis.
Erste Ansätze einer Transplantation des oralen Biofilms gibt es bereits [Nascimento, 2017]. Es gibt dabei prinzipiell zwei Möglichkeiten: die Übertragung der gesunden Flora eines Spenders oder die Übertragung einer – quasi am Reißbrett entworfenen – Idealflora. Die Übertragung von einem Spender hat natürlich eine etwas unappetitliche Komponente und ihr mangelt es an Reproduzierbarkeit und Sicherheit. Dafür können hier mikrobielle Lebensgemeinschaften übertragen werden, die perfekt aufeinander eingespielt auch Arten enthalten, die isoliert in Kultur nicht anzüchtbar sind und daher nicht künstlich hinzugefügt werden könnten. Eine industriell herstellbare Mundgesund-Flora erscheint da realistischer – ein Vorbild könnte die von Forschern um den Mikrobiologen Tomas de Wouters an der ETH Zürich entwickelte künstliche Darmflora sein, mit der Darm- und Allgemeinerkrankungen therapiert werden sollen. Von der Mikrobiomforschung und ihren therapeutischen Möglichkeiten zur Kariesprävention ist insofern noch einiges zu erwarten.
Literaturliste:
1. Conrads G, Wendt LK, Hetrodt F et al. Deep sequencing of biofilm microbiomes on dental composite materials. J Oral Microbiol 2019a; 11: 1617013
2. Dewhirst FE, Chen T, Izard J et al. The human oral microbiome. J Bacteriol 2010; 192: 5002-5017
3. Schläfer S, Raarup MK, Meyer RL et al. pH landscapes in a novel five-species model of early dental biofilm. PLoS One 2011; 6: e25299
4. Bandara H, Panduwawala CP, Samaranayake LP. Biodiversity of the human oral mycobiome in health and disease. Oral Dis 2019; 25: 363-371
5. Horz HP, Conrads G. Methanogenic Archaea and oral infections - ways to unravel the black box. J Oral Microbiol 2011; 3
6. Lauritano D, Lo Muzio L, Gaudio RM et al. The ecological catastrophe of oral diseases: a possible link between periodontitis and protozoa. J Biol Regul Homeost Agents 2016; 30: 143-147
7. Motlagh AM, Bhattacharjee AS, Goel R. Biofilm control with natural and genetically-modified phages. World J Microbiol Biotechnol 2016; 32: 67
8. Zijnge V, van Leeuwen MB, Degener JE et al. Oral biofilm architecture on natural teeth. PLoS One 2010; 5: e9321
9. Lagerweij M, van Loveren C. Chapter 7: Sugar and Dental Caries. Monogr Oral Sci 2020; 28: 68-76
10. Marshall TA. Dietary Implications for Dental Caries: A Practical Approach on Dietary Counseling. Dent Clin North Am 2019; 63: 595-605
11. Walther C, Meyer-Lueckel H, Conrads G et al. Correlation between relative bacterial activity and lactate dehydrogenase gene expression of co-cultures in vitro. Clin Oral Investig 2019; 23: 1225-1235
12. Conrads G, de Soet JJ, Song L et al. Comparing the cariogenic species Streptococcus sobrinus and S. mutans on whole genome level. J Oral Microbiol 2014; 6: 26189
13. Song L, Wang W, Conrads G et al. Genetic variability of mutans streptococci revealed by wide whole-genome sequencing. BMC Genomics 2013; 14: 430
14. Henne K, Rheinberg A, Melzer-Krick B et al. Aciduric microbial taxa including Scardovia wiggsiae and Bifidobacterium spp. in caries and caries free subjects. Anaerobe 2015; 35: 60-65
15. Takahashi N, Nyvad B. The role of bacteria in the caries process: ecological perspectives. J Dent Res 2011; 90: 294-303
16. Wolff D, Frese C, Schoilew K et al. Amplicon-based microbiome study highlights the loss of diversity and the establishment of a set of species in patients with dentin caries. PLoS One 2019; 14: e0219714
17. Kressirer CA, Smith DJ, King WF et al. Scardovia wiggsiae and its potential role as a caries pathogen. J Oral Biosci 2017; 59: 135-141
18. Tanner AC, Kent RL, Jr., Holgerson PL et al. Microbiota of severe early childhood caries before and after therapy. J Dent Res 2011; 90: 1298-1305
19. Koo H, Xiao J, Klein MI. Extracellular polysaccharides matrix--an often forgotten virulence factor in oral biofilm research. Int J Oral Sci 2009; 1: 229-234
20. Camelo-Castillo A, Benitez-Paez A, Belda-Ferre P et al. Streptococcus dentisani sp. nov., a novel member of the mitis group. Int J Syst Evol Microbiol 2014; 64: 60-65
21. Conrads G, Westenberger J, Lurkens M et al. Isolation and Bacteriocin-Related Typing of Streptococcus dentisani. Front Cell Infect Microbiol 2019b; 9: 110
22. Nascimento MM. Oral microbiota transplant: a potential new therapy for oral diseases. J Calif Dent Assoc 2017; 45: 565-568